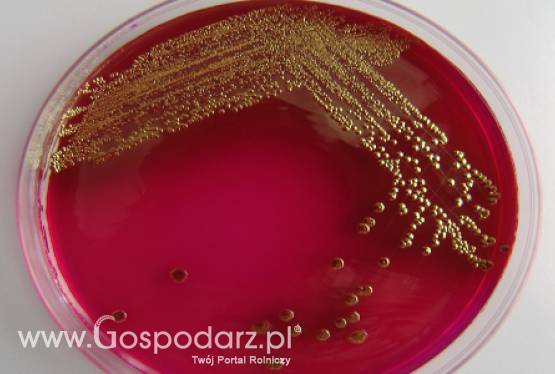
Białoruś – Wstrzymano dostawę unijnych warzyw do Rosji

Rosja - Nadal nie wstrzymano zakazu importu warzyw z UE
Wprowadzony przez Rosję zakaz importu warzyw pochodzących z Europy, który był odpowiedzią na falę zakażeń bakterią E. coli, stał się przyczyną komplikacji w sprawie członkostwa tego kraju w Światowej Organizacji Handlu (WTO).